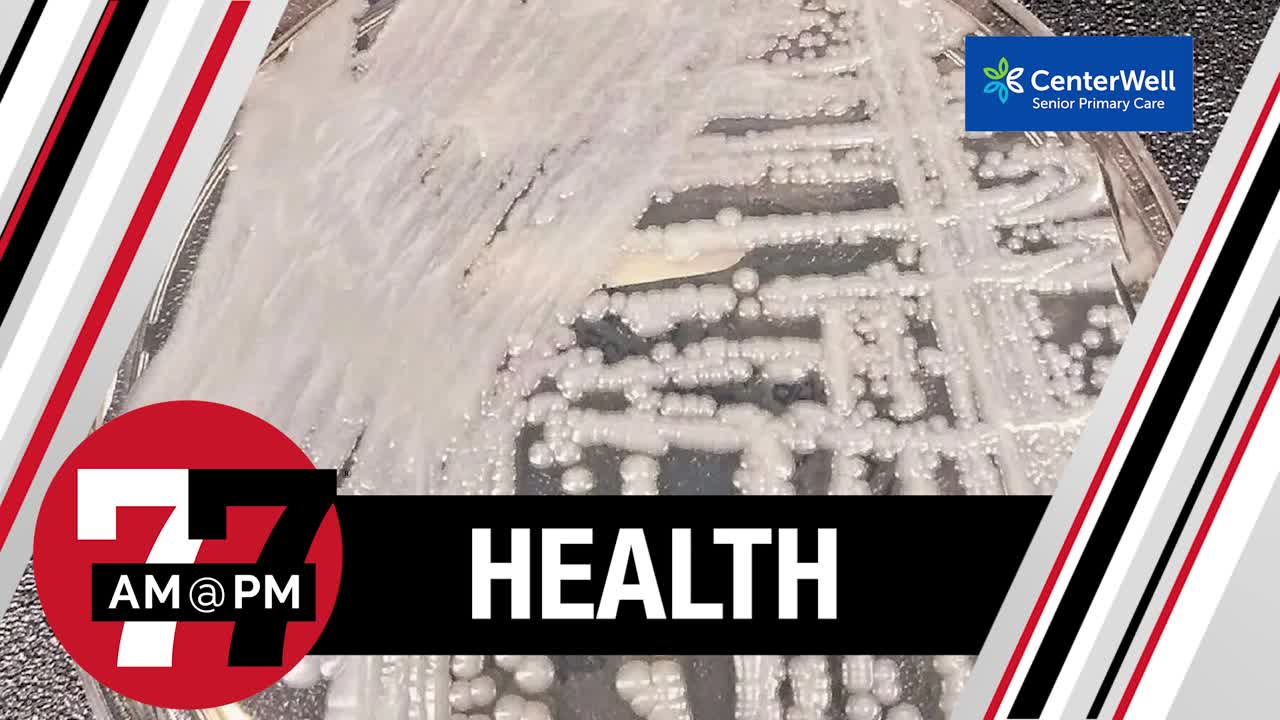
Candida Auris still dangerous for Nevada

Wondering how to watch 7@7 through streaming apps on your phone and TV?
Downloading the Review-Journal news app is easier than you think. Simply click on your preferred streaming app below for a brief video on how to search and download 7@7.
7@7 Videos